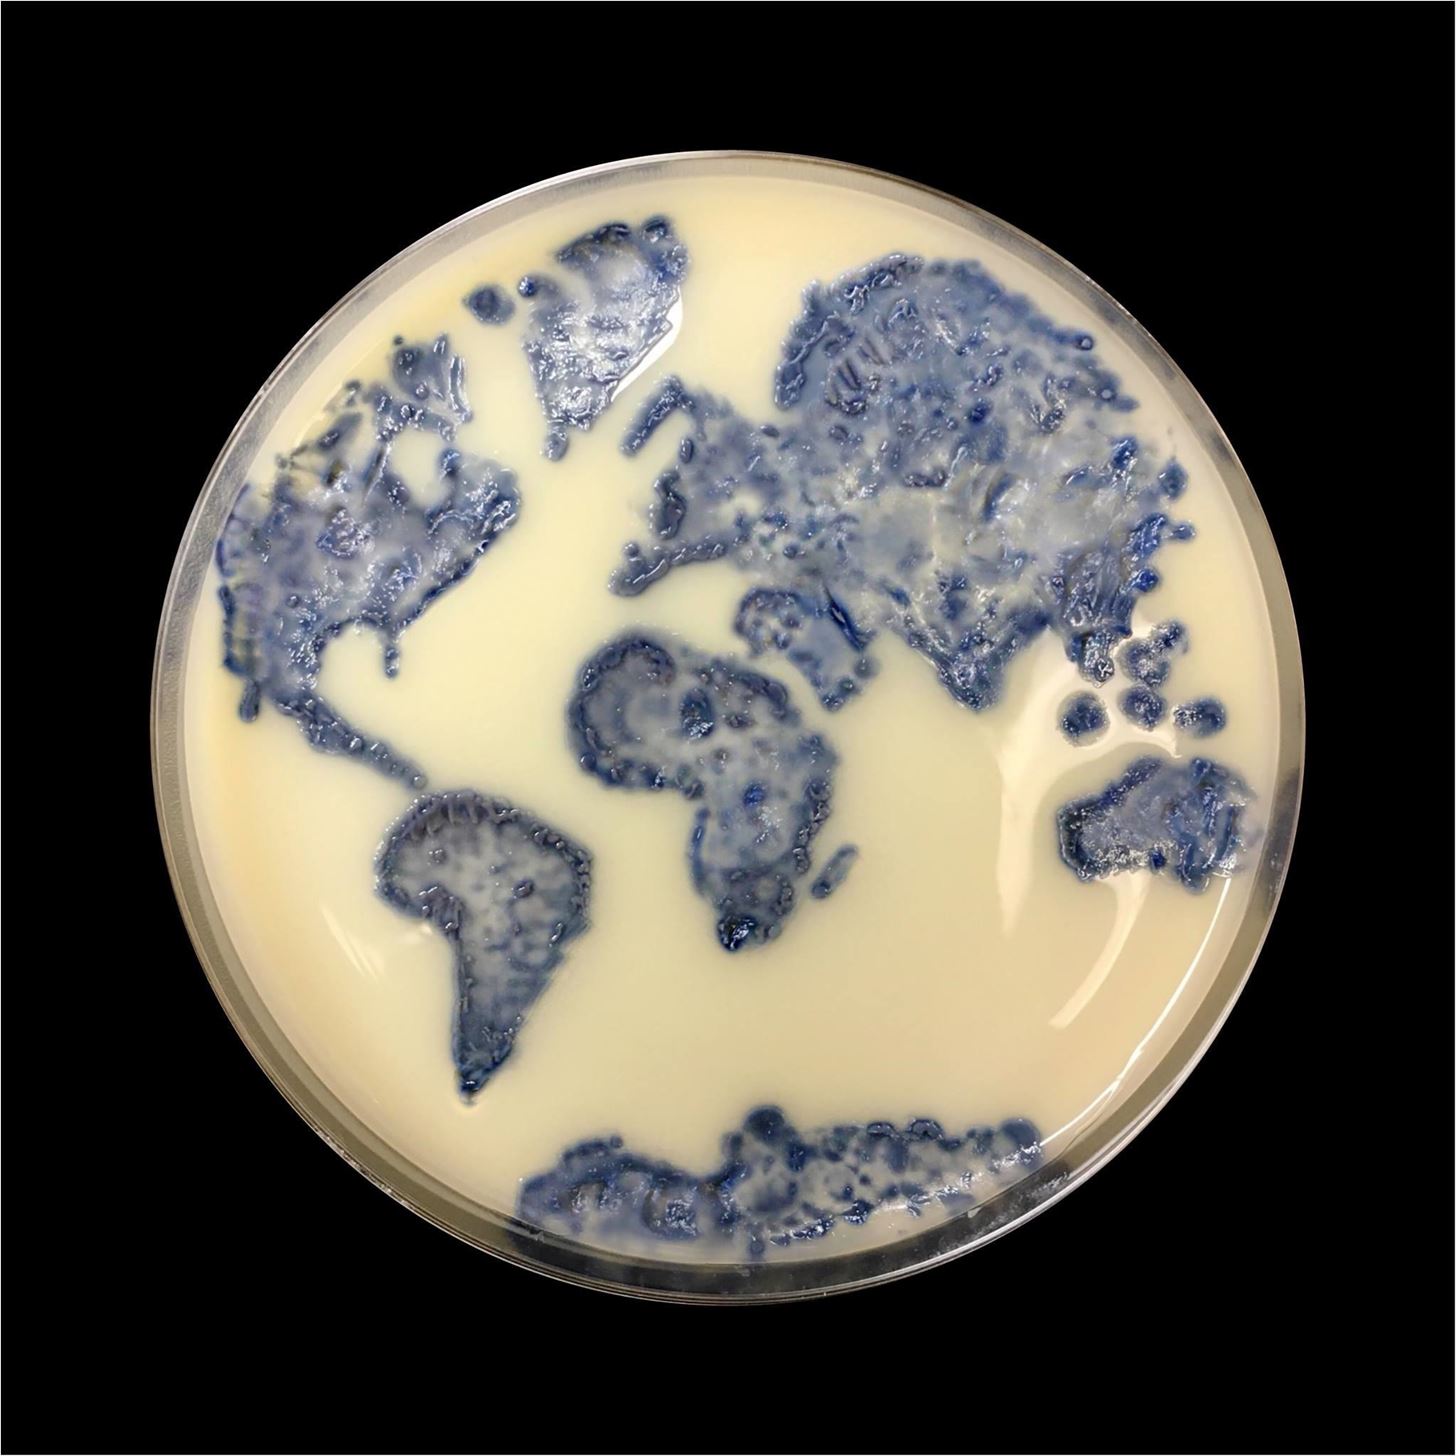
1456x1456 our favorite bacteria art submissions from asm's petri dish - Petri Dish Drawing

'Favorite' tagged drawings images
Most Downloads Size Popular
Images: 100 Downloads: 101 Likes: 10

320x320 my favorite starter pokemon! bulbasaur tell me what ur favorite is - Pokemon Pencil Drawing
0 0

2480x3508 his favorite show is sheriff callie's wild west and his favorite - Sheriff Callie Drawing
0 0

1120x1104 my favorite illustrations pen ink petrographic drawings life - Metamorphic Rock Drawing
0 0

500x492 minecraft in cartoon versionmy favorite is the zombie pigman - Minecraft Cartoon Drawings
0 1

870x492 good drawing of squid,finnball,stamy,lee, and my least favorite - Minecraft Stampy Drawings
0 0

425x400 it's pretty much my favorite animal it's like a lion and a tiger - Napoleon Dynamite Drawing
0 0

1000x794 favorite native american eagle art advancedmassagebysara - Native American Eagle Drawing
0 0

768x1024 for someone who's favorite race is halfling, i sure draw a lot - Picture Of Someone Drawing
0 0

468x293 create a police sketch of your favorite face with this excellent - Police Drawing Software
0 0

1191x921 these realistic drawings of some of your favorite childhood - Realistic Cartoon Drawings
0 0

1300x1300 top black and red dress shoes on hanger my favorite little drawing - Red Dress Drawing
0 0

3000x2250 i started to draw my favorite rick and morty scene rickandmorty - Rick And Morty Drawing
0 0